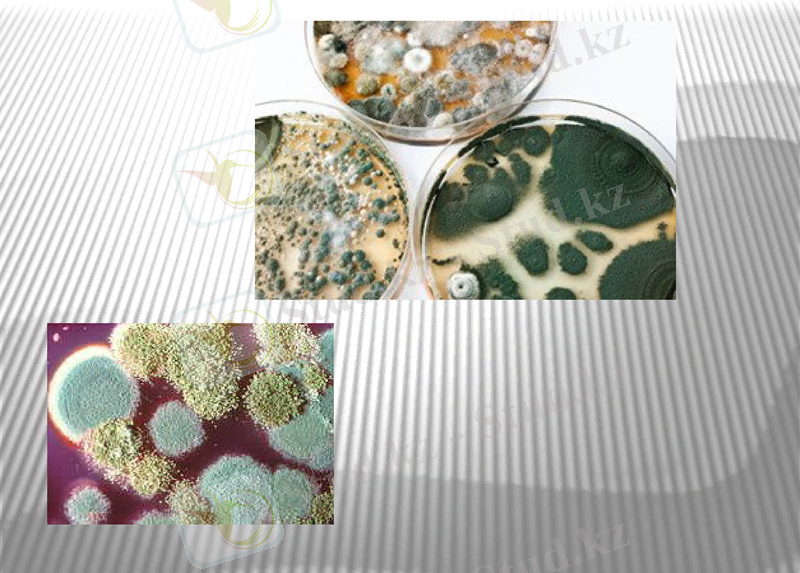
Slide 2

Жануарлардағы микотоксикоздар: этиологиясы, патогенезі және клиникалық белгілері



Микотоксикоздар

Патогенді саңырауқұлақтар ағзаға әсер ету механизміне байланысты 2 топқа бөлінеді:
1. микоздар - саңырауқұлақтардың тікелей малдарды уландыруы.
2. микотоксикоздар - ағзаға енген саңырауқұлақтардан бөлінген токсиндердің уытты әсері.
Зең саңырауқұлақтарымен зақымданған жем-шөптермен улану.
Ықпал ететін жағдайлар: 18-30 пайызды ылғалдылық көбінесе дәнді -дақылдар беде-жоңышқа зақымдалады. Зең саңырауқұлақтарымен зақымданған жем-шөптердің түсі қараяды және бурыл түсті болады, қышқыл иісті.

Патогенезі. Жем-шөп арқылы асқорыту жолына түседі немесе өсімдіктердің шаң-тозаңы арқылы тыныс алу жүйесіне барады. Кілегейлі қабықтарда өсіп, дамып тереңірек ене түседі. Қан арқылы бүкіл организмге тарайды.
Уыттылығы саңырауқұлақ түріне, олардың вируленттілігіне, малдың физиологиялық жағдайына, жеке сезімталдығына, азықтануына, азықтың зақымдану дәрежесіне, саңырауқұлақтың химиялық құрамына байланысты.
Клиникасы: Жылқыда 3 түрлі формада өтеді: өтпелі, ішекті және милы. Көбінесе олар бірге кездеседі. Жіті гастроэнтерит, саливация, баспаның (ангина) асқынған түрі, мойын лимфа түйіндері ісінеді, мойын және бас бұлшық еттері тартылады, коликтер, іш қатады немесе өтеді, нәжіс жағымсыз иісті, қан немесе шырыш аралас, тыныс алу жиілейді, тамыр соғуы әлсіз, температура - 41ºС, бүйрек қабынады, әлсіздік, атония, артқы аяқтары салданады, қарашықтары кеңейеді. Ірі қарада сонымен қатар тимпания, іш тастайды.
Негізінен микозды аурулар тез арада пайда болады және клиникалық белгілері бірден байқала бастайды. Тыныс алу жүйесі тұрғысынан өкпенің эмфиземасы, стоматит, пневмония, энцефаломиелит, жөтел, сырыл пайда болуы мүмкін.

Патологиялық-анатомиялық өзгерістері. Бауырдың токсикалық дистрофиясы, асқазанның кілегейлі қабықтарында қатпарлы қабынуы, талақ және лимфа түйіндерінің үлкейуі, эпикардта қан ұюлар, өкпе гиперемиясы, оның ісінуі, трахея мен бронхта көбіктенген сұйықтықтың пайда болуы сияқты белгілер байқауға болады.

Микотоксикоздар дегеніміз - жануарлар ағзасына микоз тәріздес уытты заттардың (саңырауқұлақтар) енуі нәтижесінде пайда болатын ауылшаруашылық малының аурулары. Оларға: аспергилло-, дендрохио-, стахиоботрио- және фузариотоксикоздар жатады.
Аспергиллотоксикоздар - аспергиллюс туысына жататын (20-астам) уытты саңырауқұлақ әсерінен пайда болатын аурулар. Олар ылғалдылығы 18 ден 35 градус аралығындағы жемдерде пайда болып, афлотоксин деп аталатын уытты зат бөліп шығарады. Афлотоксиндер суда және органикалық ертінділерде жақсы ериді. Судағы ерітінділері жоғары температураға төзімсіз, күн сәулесіне төзімді. Қышқылдар мен сілтілердің әсерінен белсенділігін жояды.
Токсикологиясы. Малдың организміне ене отырып афлотоксиндер бауырдың функционалдық қызметін бүлдіреді, кейбір ферменттердің белсенділігін төмендетеді, РНК-ның метаболизмін өзгертеді, белоктардың синтезін бұзады, мүшелерді майлы және белоктық дистрофияға ұшыратады, гепатоцидтерді өліеттедіреді, канцерогенді, тератогенді және мутагенді әсер етеді.


Клиникасы. Алғашқы белгілері 1-3 күннен кейін байқала бастайды. Улану жіті, жітілеу және созылмалы түрде кездеседі.
Жылқыларда аздаған қозу пайда болып, ол тежелу сатысына алмасады. Жем-шөптен қалады, шөлдейді. Ауыз қуысының кілегейлі қабықтары қызарады, ішектің перистальтикасы күшейеді, нәжіс кілегейлі заттармен араласады. Температура төмендейді, тамыр соғуы және тыныс алу жиілейді, мал жатаған келеді, бұлшық еттері тартылады.
Ірі қарада алғашқы белгілер 4-6 күннен кейін пайда болады. Көз қарашығы үлкейеді, бұлшық еттері тартылады, құлақтарының ұштары, аяқтарында, бас терілерінде өліеттенулер көрінеді, жалпы әлсірейді, кілегейлі қабықтар сарғаяды, тәбеті төмендейді, сілекей көп бөлінеді, жөтеледі, тремор, асқорыту және жүйке жүйесі жұмысы нашарлайды. Буаз мал іш тастайды, бұзаулардың іші өтеді, тамыр соғуы және тыныс алуы жиілейді.
Қойларда: Жалпы әлсірейді, тәбеті төмендейді, саливация, несеп бөлу жиілейді, гипотония, атония және тимпания қалыптасады, қарын ісінеді.
Шошқаларда: Жалпы қозу, атаксия, тремор, іш өту, парез секілді белгілерімен қатар, ас қорыту жолының функциясы бүлінеді, құсады, салданады, тілі, қызыл иегі, желінінің, құлағының ұштары, аяқтарының, бас терісінің кейбір бөліктері өліеттенеді.
Құстарда: Жалпы әлсірейді, тәбеті төмендейді, айдары мен сырғалығы көгереді.

Патологиялық-анатомиялық өзгерістері. Кілегейлі қабықтар катаральді түрде қабынады, асқазан мен кейбір ішектердің кілегейлі қабықтары өліеттенеді. Бауыр үлкейеді, жүректе қан ұйюлар байқалады, өкпесі қызарған әрі ісінген. Миы қанға толы, паренхимтозды мүшелерде дистрофиялық өзгерістер білінеді. Бронхтар мен бронхиолалар көбіктенген, қан аралас сұйықтыққа толы.
Емдеу және алдын алу шаралары. Рационнан аспергилл штамдарымен зақымданған азықты алып алып тастау керек. Адсорбенттер, құстырғыштар, іш өткізгіштер береді. Сіресуге қарсы тері астына 2-10, 0 мл, 30 пайызды магний сульфатын, глюкоза егуге болады. Дәндердің тазалығын анықтау үшін натрий хлоридімен талдау жүргізеді. 4 кг натрий хлоридін алып, оны 10 л суға ерітеді. Алынған дәндерді осы дайындалған ерітіндіге салады. Егер де қастауыш мүйізшелері бар болса, онда олар судың бетіне шығады.

Дендродохиотоксикоз - жіті және жітілеу түрде өтетін ауру. Көбінесе жылқы, шошқа, қой және құстар уланады. Дендрохин саңырауқұлақтары бидайдың, қара бидайдың, сұлының және арпаның сабанының ішінде өмір сүріп, улылық қасиет көрсетеді. Сондықтан, сабанның сыртқы көрінісі ешбір зақымданбаған болып көрінеді. Бөлінетін токсиндер химиялық заттарға және жоғары температураға өте төзімді.
Клиникалық белгілері. Улану ауыр түрде өтеді. Жылқыларда жалпы қажу, тамыр соғуының жиілеуі, ауыз қуысы кілегей қабығының қабынуы, еріннің ісінуі, қанның формалық элементтерінің санының көбейюі сияқты белгілер білінеді.
Қойларда уланудың жіті түрінде лейкоцитоз, гипотония, тремор байқалып, кейбір кездері дене қызуы көтеріледі. Ал жітілеу түрінде еріндері өлі еттеніп, жүйке жүйесі зақымданады.
Шошқаларда әлсіздік, қозғалысының бұзылуы, тәбетінің жойылуы, шөлдеу, құсу, іш өту, дірілдеу, ауыз қуысы кілегей қабықтарының, ернінің және тұмсығының қан талауы, қанда эритроциттердің санының көбеюі секілді белгілер байқалады.
Патологиялық- анатомиялық өзгерістер. Өлексе сіресіп қалады. Көзге көрінетін кілегей қабықтардың көгергенін көруге болады. Ішектің кілегейлі қабығы катаральды қабынады. Сонымен қатар өт қабының өтке толғанын, өкпенің ісінгенін, паранхиматозды мүшелердің дисстрофиялық өзгерістерін байқауға болады.
Балау - анамнез деректеріне, клиникалық белгілеріне, патологиялық- анатомиялық өзгерістеріне және зертханалық тексеру қорытындыларына қарай қойылады.
Емдеу. Рационнан саңырауқұлақтармен зақымданған азықтарды алып, ішек-қарынды тазартады. Іш өткізгіш дәрілік заттар қолдануға болады. Кофеин - бензоат натриді глюкозамен қосып, венаға егеді. 1-2 күн малды диетада ұстаған дұрыс.


Клавицепстоксикоз - клавицепс туысы саңырауқұлақтарынан малдардың улануы. Бұл саңырауқұлақтар туысына күйісті малдар, жылқы және шошқа аса сезімтал келеді. Саңырауқұлақ мәдени және астық тұқымдас өсімдіктер дәндерімен бірге ішке түсіп (микоз), токсин бөледі (микотоксикоз) .
Микотоксикоз екіге бөлінеді:
Эрготизм
.


Қастауыштан улану - эрготизм (Спорынья) .
Астық тұқымдастардың дәндерінде пайда болатын қастауыш алколоидтарынан улануды - эрготизм дейді. Жауын-шашын жылдары мәдени өсімдіктердің, арпа, сұлы дәндерінің, диірмен қалдықтарының қастауыштан ластануы жиі кездеседі. Малдар үшін қауіптісі саңырауқұлақтың құрамында болатын уы - склероцин. Уытты бастамасы - эрготоалколойдтар: эрготоксин, эрготамин, эргозин. Олар бірыңғай салалы бұлшық еттерге әсер етеді. Қарашықты тарылтады, қантамырларын тарылтып, ұлпалардың қоректенуін бүлдіреді (цианоз, некроз), симптоматикалық жүйке жүйесін тежейді. Сезімтал мал: үй жануарлары - шошқа, ірі қара, құстар.
Клиникалық белгілері. Улану жіті және созылмалы түрде өтеді. Жіті түрінде асқорыту жолының қызметі бұзылады, сілекейі ағады, ауыз қуысының кілегейлі қабықтары қабынады, құсады, коликтер, іш өту, сезімталдықтың төмендеуі, немесе жойылуы, сіресепелер байқалады. Бұлшық еттері дірілдеп, тартылып қалады, көз қарашығы кеңейеді, қозғаласы нашарлайды. Созылмалы түрі - құрғақ гангрена түрінде білініп, құстардың айдарымен сырғалығы, ірі қара малдың желініңің ұштары, құйрығы, кейде тұяқтары, шошқалардың тұмсығы, бас терілері шіріп, түсіп қалады.
Патологиялық-анатомиялық өзгерістері. Сойып, зерттегенде ішкі мүшелерде қан айналудың бұзылуы белгілерін, теріде некрозды ошақтар қөруге болады.
Емі. Рационнан қастауышпен ластанған азықты жедел алып тастаған жөн. Жайылымдарды уақытында тексеруден өткізіп, оны агротехникалық әдістермен арам шөптерден және қастауыштан тазартып тұрған дұрыс. Егер мал улана қалған жағдайда адсорбенттер, құстырғыш заттар, іш өткізгіштер қолданады. Сіреспеге қарсы 30%-ды магний сульфатын 2-10мл мөлшерінде тері астына егеді.


- бұл жануарлардың бірден көптеген бөлігінде болатын ауруы. Ол жайылым кезінде де, сондай-ақ байлаулы кезінде де байқалады.
Клиникалық белгілері. Жылқыда: жалпы әлсіреу, атаксия, тремор және әртүрлі салданулар білінеді. Кілегейлі қабықтар қызарады, тамыр соғуы жиілейді, температура төмендейді.
Ірі қарада: үркектік пайда болады, басын шайқай береді, атаксия, тремор, парездер қалыптасады. Созылмалы түрінде зат алмасу бұзылып, арықтайды, өсімталдығы төмендейді.
Қойда :тремор, жалпы қозу, парез, тамыр соғуының жиілеуі, кілегейлі қабықта гиперемия, бедеулік, агалактия секілді белгілер байқалады.
Патологиялық-анатомиялық өзгерістері: Паренхиматозды мүшелерде іркілдектер пайда болады. Бауыр мен өкпе қанға толы. Лимфа бездері үлкейген. Қарынның кілегейлі қабықтары ісінеді, қызарады.
Емдеу, алдын алу шаралары: Жем-шөпті тексеріп, асқазанды тазалау керек, іш өткізгіштер, адсорбенттер, кілегейлі заттар, сіресуге қарсы заттар беріледі.


Фузариотоксикоз дегеніміз - Fusarium туысына жататын улы саңырауқұлақтардан зақымдалған азықты малға бергенде туатын улану. Соңғы мәліметтер бойынша фузариотоксикоз этиологиясында, саңырауқұлақ Fus. Sporotrichiella үлкен роль атқарады.
Fus. Sporotrichiella көп тараған бірі, әртүрлі өсімдіктерде мекендейді. Көбінесе өсімдік дәндері зақымданады.
Фузариотоксикоз кәзіргі кезде жануарлар ішінде жиі кездесетін микотоксикоздар.
Ауруға ауылшаруашылық малдары мен құстары бейім. Ірі қара және ұсақ мал төзімді, тек қышқыл азықты (сүрлем, қызылша сығындысы) көп мөлшерде бергенде уланады. Ауруға жас және буаз малдар сезімтал келеді.
Н. А. Спесивцеваның мәліметтері бойынша, жылқының фузариотоксикоздан уланып өлуі, көптеген шаруашылықтарда малдың жалпы санының 65-75%-ын құрайды. Әсіресе шошқалар мен құстарда фузариотоксикоздан уланып өлу, үлкен пайызды көрсетеді.
Жылқыларда фузариотоксикоздан улану дәнді азықтарды бергенде жиі кездескен.
А. П. Онегов және Н. А. Наумов құлындар мен торайларға қыстан қалған астық туқымдас дақылдарды бергеннен кейінгі (сұлыны) токсикологиялық әсерін зерттеп, олардың улануы кезінде, ойық-жара, өліеттену процестер (стоматит, гастроэнтерит, дерматит) және де жүйке жүйесінің бұзылуы секілді белгілер байқаған.

Fusarium туысының саңырауқұлақтары табиғатта кең тараған және кейбір түрлері бидайды жиі зақымдайды. Бидайдың зақымдалуына 18-27 C температура және бидай ылғалдылығы (20-25%) әсер етеді. Сонымен қатар, санырауқұлақтардың кейбір түрлері төменгі температурада да өсе береді .
Академик П. Е. Сергеевтің пікірі бойынша, егістікте қалған астық тұқымдастардың жоғары ылғалдылығы 0-10°С температурада Fus. sporothirichioides саңырауқұлағының өсуіне қолайлы жағдай туғызады.
А. Х. Саркисов және Е. С. Квашнин егістікте қыстан шыққан астық тұқымдастардың әртүрлі жануарларға уыттылығын зерттеген.
Әртүрлі аудандардан әкелінген уытты дәндердің 107 үлгісінің микрофлорасын зерттегенде және саңырауқұлақтардың 250 түрінің ішінде ең уытты болып Fus. Sporotrichiella саңырауқұлағы болып шықты.
Улану себебі барлық азықтардың зақымдануына байланысты: сабан, шөп, дәндер, астық тұқымдастар ұны, құрама жем, кебек.
Астық тұқымдастар алқабында ірі қара малдар жайылғанда барлығы фузариотоксикозға шалдыққаны белгілі.
Fus. Sporotrichiella саңырауқұлақтарымен зақымдалған құрама жемді шошқаға және құсқа бергенде жіті және созылмалы улану байқалған.

Фузариотоксикоздың ерекшелігі, қысқы мерзімнің өзінде (1-3 күнде) жануарлардың көпшілігі ауырады.
Фузариотоксикоз толық зерттелмеген. Біздің елімізде Л. Е. Олифеонов осы бағытта зерттеулер жүргізген. Ол дәнді F. Sporotrichiella-мен зақымдап, одан токсикалық стероидтар-енорофузариогенин және ноофузариогенин бөліп алған. Олар жақын болып келеді.
Фузариотоксикоздар әсері бойынша жалпы токсикалық және дермацидтік уларға тән. В. И. Билай оларды жалпы плазматикалық әсері бар уларға жатқызады. Фузариотоксикоздардың әсер ету механизміне қарай И. Куршанов оларды орталық және вегетативтік жүйке жүйесіне әсер ететін жалпы токсикалық улардеп екіге бөледі.
Улану кезіндегі белгілер төмендегідей: мал мазасызданады, ауырсынуы байқалмайды, рефлекстер жоқ, ішек-қарын жолының моторлық қызметі және жүрек тамыр жүйесінің жұмысы бұзылады. Сонымен қатар қан түзетін мүшелердің жұмысын өзгертеді, соның салдарынан қанның морфологиялық құрамы өзгереді, лейкопения дамиды.
Зақымданған азықты ұзақ уақыт беру жүрек-қан тамыр жүйесіне әсер етіп, қан айналымында өзгерістер тудырады. Соның салдарынан геморрагиялық диатез, өкпе домбығуы қалыптасады.
Ауру азықтың саңырауқұлақтардан зақымдалуына байланысты жіті, жітілеу және созылмалы түрде өтеді. Ауырған мал ішінде өлім-жітім жоғары болады. Зерттеулер мәліметі бойынша, улану 2-9 күнге созылып, ақыры өліммен аяқталады. Ірі қара мал жіті уланғанда 2-3 күнде өлімге ұшыраған. Өлтіре әсер ететін мөлшері: жылқыға 0, 5-4, 6 кг, ірі қара малға 0, 5-4, 8 кг, ұсақ малдарға 0, 4-1, 2 кг, шошқаларға 0, 25-0, 9 кг.

Клиникалық белгілері. Зерттеушілердің мәліметтері бойынша фузариотоксикоздың жіті және жітілеу түрінде, жылқы мен ірі қарадағы алғашқы белгілер орталық жүйке жүйесінің зақымдалуымен сипатталады. Уланудың алғашқы күндерінде мал мазасызданады, тері сезімталдығы және рефлекстер жоғалады немесе төмендейді, дененің алдыңғы бөлігінде бұлшықет дірілі байқалады. Ауру дами келе артқы бөлігі салданады. Жылқы жатқан жерінен тұра алмай қалады.
Жүрек жұмысы бұзылады, тамыр соғуы жиілейді (жылқыда 100-1 минутта) және аритмия байқалады. Температурасы межеден 0, 5-7-ке төмендейді. Ішек қарын жұмысы бұзылған. Ірі қара малда мес қарын атониясы, ішек қарын перистальтикасы күшейген. Жылқыда шайнау және жұтынуы қиындайды, ішек қарын перистальтикасы бәсеңдеп, іш қату байқалады.
Фузариотоксикоз кезінде қанда өзгерістер болады. А. Е. Цветкованың мәліметтері бойынша эритроциттері 1-1, 5 млн, лейкоциттер 200-ге дейін азайған.

Коньюктива, ауыз және танау қуысының кілегейлі қабығы бозарып, кейде сарғаяады. Дене температурасы 39-39, 60С, тамыр соғуы және тыныс алуы жиілейді. Ішектің перистальтикасы күшейеді. Қой арықтайды, сыртқы тітіркендіргіштерге көңіл бөлмейді.
Шошқалар мазасызданады, азықты қабылдамайды, іші өтеді, кейде құсады. Кейбір жағдайда ойық жаралы стоматит қалыптасып, басы, мойны ісінеді, қызыл дақтар болады.
- Іс жүргізу
- Автоматтандыру, Техника
- Алғашқы әскери дайындық
- Астрономия
- Ауыл шаруашылығы
- Банк ісі
- Бизнесті бағалау
- Биология
- Бухгалтерлік іс
- Валеология
- Ветеринария
- География
- Геология, Геофизика, Геодезия
- Дін
- Ет, сүт, шарап өнімдері
- Жалпы тарих
- Жер кадастрі, Жылжымайтын мүлік
- Журналистика
- Информатика
- Кеден ісі
- Маркетинг
- Математика, Геометрия
- Медицина
- Мемлекеттік басқару
- Менеджмент
- Мұнай, Газ
- Мұрағат ісі
- Мәдениеттану
- ОБЖ (Основы безопасности жизнедеятельности)
- Педагогика
- Полиграфия
- Психология
- Салық
- Саясаттану
- Сақтандыру
- Сертификаттау, стандарттау
- Социология, Демография
- Спорт
- Статистика
- Тілтану, Филология
- Тарихи тұлғалар
- Тау-кен ісі
- Транспорт
- Туризм
- Физика
- Философия
- Халықаралық қатынастар
- Химия
- Экология, Қоршаған ортаны қорғау
- Экономика
- Экономикалық география
- Электротехника
- Қазақстан тарихы
- Қаржы
- Құрылыс
- Құқық, Криминалистика
- Әдебиет
- Өнер, музыка
- Өнеркәсіп, Өндіріс
Қазақ тілінде жазылған рефераттар, курстық жұмыстар, дипломдық жұмыстар бойынша біздің қор #1 болып табылады.



Ақпарат
Қосымша
Email: info@stud.kz